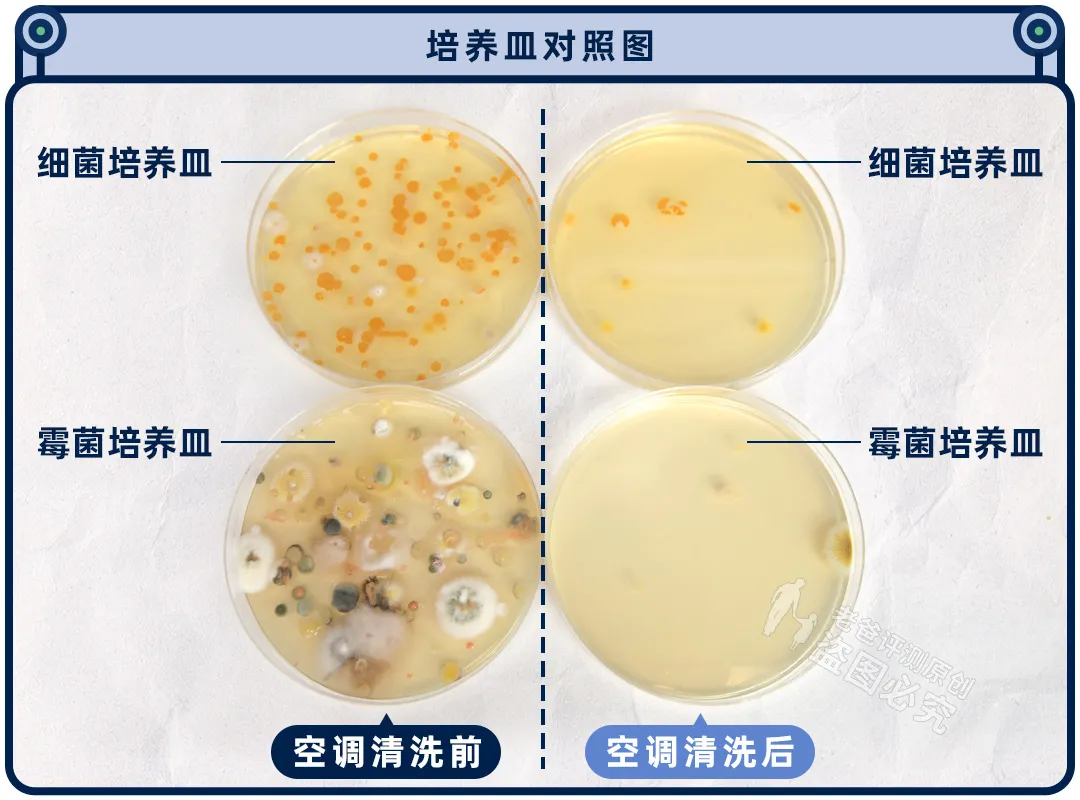

今天是: 福州市疾病预防控制中心欢迎您!
最近的气温升高。许多市民已经开始使用空调了。且慢……你知道1年没清洗过的空调有多脏吗?
研究人员分别在空调正式清洗前和清洗后,用培养皿在空调出风口吹上 5 分钟,三天后对比结果如下:
一、空调不清洗的健康隐患
1.细菌与霉菌滋生
长期未清洗的空调过滤网、散热片和蒸发器会积聚大量灰尘、细菌和霉菌。研究显示,88%的空调散热片细菌总数超标,部分细菌浓度甚至超过标准近40倍。空调内部潮湿环境易滋生真菌(如曲霉菌、青霉菌)和细菌(如葡萄球菌、军团菌),可能引发哮喘、肺炎、皮肤过敏等疾病。极端案例中,未清洗的空调甚至导致嗜肺军团菌感染,危及生命。
2.空调病的诱因
空调病表现为鼻塞、头痛、乏力等症状,与空调房内微生物传播、空气干燥及温差过大密切相关。
二、空调清洗的四大益处
1.预防呼吸道疾病
定期清洗可减少细菌扩散,降低鼻炎、哮喘等呼吸道疾病风险。
2.提升制冷效率
污垢堵塞散热片会降低制冷效果,清洗后空调耗电量可减少10%~30%。
3.延长使用寿命
避免因灰尘堆积导致的压缩机超负荷运转,减少故障率。
4.改善空气质量
清除异味和灰尘,确保送风清洁。
三、空调清洗的正确步骤(以家用壁挂式为例)
1.断电与防护
关闭电源并拔掉插头,确保安全。
2.清洁过滤网
取下过滤网,用软毛刷清除表面灰尘,中性清洁剂浸泡15分钟后冲洗晾干(勿暴晒)。
3.深度清洁蒸发器
使用专用泡沫清洗剂喷洒蒸发器翅片,静置5分钟后擦净,避免损伤铝片。
4.清洁外壳与出风口
湿布擦拭外壳和导风板,棉签清理缝隙。
5.试运行
装回部件后,开启送风模式15分钟排出残留水分。
四、常见误区与注意事项
1.误区一:仅清洗过滤网
蒸发器、风轮等内部部件才是细菌重灾区,需重点清洁。
2.误区二:滥用消毒剂
84消毒液等强腐蚀性清洁剂可能损坏金属部件,建议使用中性清洁剂。
3.误区三:忽视干燥环节
未完全干燥即开机可能引发短路,需晾干后再使用。
五、清洗频率建议
家庭使用:每年至少清洗2次(夏季和冬季使用前)。
高频使用环境:每月清洁过滤网,每3个月深度清洗一次。
特殊人群家庭:有婴幼儿、老人或呼吸道疾病患者的家庭,建议增加清洗频率。
六、专业清洗的必要性
非专业人员易忽略内部部件清洁(如蒸发器、风轮),且缺乏高温蒸汽设备,灭菌效果有限。
复杂机型(如中央空调)建议联系售后或专业团队处理。
参考来源:科普中国、中国数字科技馆、成都新时报等
供稿:卫生应急处置科
一审:姚丽钦
二审:詹文青
三审:罗柏友
Copyright 2009 福州市疾病预防控制中心 All Rights Reserved
福州市疾病预防控制中心 主办
公安备案号:35010202001851 闽ICP备11009988号
联系方式:0591-63039912 | 隐私保护